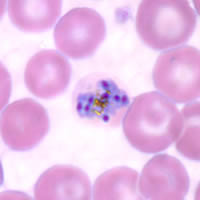
Schizonts of P. malariae in a thin blood smear.
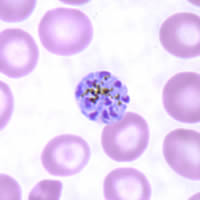
Schizonts of P. malariae in a thin blood smear.

|
|
[Last Modified: ] |
|
|
|
| [Plasmodium
falciparum] [Plasmodium malariae] [Plasmodium ovale] [Plasmodium vivax] |
|
Plasmodium malariae: Schizonts
Smears from patients:
Plasmodium malariae schizonts have 6 to 12 merozoites with large nuclei, clustered around a mass of coarse, dark-brown pigment. Merozoites can occasionally be arranged as a rosette pattern. The red blood cells (RBCs) are normal to smaller than normal (3/4 ×) in size.
|
|
 |
| A | B | C |
A, B, C: Schizonts of P. malariae in thin blood smears. C has the appearance of a rosette pattern.
 |
| D |
D: Thick blood smear showing a schizont.
|
||||||||